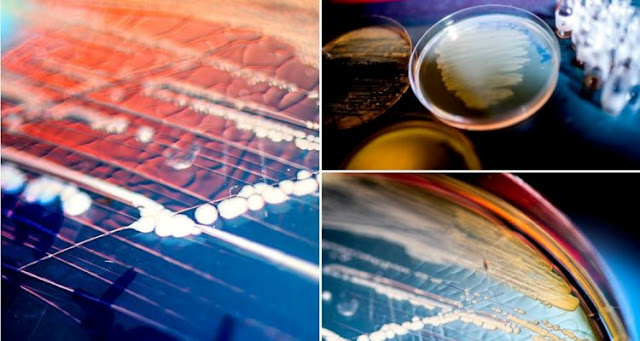

Recent years have seen the emergence of a new class of antibiotic-resistant bacteria: superbugs, and more specifically Gram-negative bacteria. As a symptom of the growing resistance of pathogens to common antibiotics, this poses a serious public health problem worldwide, as some infections have become resistant to all known antibiotics. In this context, microbiologists have highlighted a new molecule, darobactin, whose antibiotic properties could help overcome this super-resistance. Found inside a bacterium, itself hidden in the gut of nematodes, darobactine is, in the state, not applicable to humans. However, it is an extremely promising step.
After two years of research, darobactin has been discovered. The antibiotic was found in Photorhabdus bacteria , hidden in the intestines of tiny parasitic worms called nematodes.
What makes gram-negative bacteria so stubborn is their outer membrane, which acts as an additional barrier against any type of attack. Darobactin has the particularity of piercing this barrier by interfering with the BamA protein, which controls access to the outer membrane.
" Darbactin binds to this protein [BamA] and blocks it, so it can not open. Bacteria can not build an adequate cell envelope, which causes death, "said Kim Lewis, a molecular microbiologist at Northeastern University.
Darobactin: an antibiotic molecule derived from the microbiome of nematodes
In laboratory experiments, the new antibiotic was able to cure mice from the dangerous infections of Escherichia coli and Klebsiella pneumoniae without any toxic side effects. Adapting darobactin to humans will probably take a long time, but this is promising.Researchers have identified the nematode as a potential host for an effective antibiotic because of the way these worms feed on insects, target their larvae and release bacteria, which must then fight off pathogens similar to those present in the larvae. human intestine.
And this makes darobactin a promising candidate for human use. Although antibiotics in the animal microbiome have never been effective in humans, Photorhabdus has evolved over 370 million years to control gram-negative bacteria.
Antibiotic resistance: an urgent fight against gram-negative bacteria
Gram-negative bacteria are at the top of the list of priority pathogens that currently pose the greatest threat to human life. All of this is happening in the context of a broader problem of antibiotic resistance - bacteria are essentially developing defenses faster than we can develop drugs to target them.It is estimated that each year about 700,000 people die from antibiotic-resistant infections, and that number could rise to several million in the coming years.
| Bibliography: A new antibiotic selectively kills Gram-negative pathogens Yu Imai, Kirsten J. Meyer, Akira Iinishi, Quentin Favre-Godal, Robert Green, Sylvie Manuse, Mariaelena Caboni, Miho Mori, Samantha Niles, Meghan Ghiglieri, Chandrashekhar Honrao, Xiaoyu Ma, Jason Guo, Alexandros Makriyannis, Luis Linares-Otoya, Nils Böhringer, Zerlina G. Wuisan, Hundeep Kaur, Runrun Wu, Andre Mateus, Athanasios Typas, Mikhail M. Savitski, Josh L. Espinoza, Aubrie O’Rourke, Karen E. Nelson, Sebastian Hiller, Nicholas Noinaj, Till F. Schäberle, Anthony D’Onofrio & Kim Lewis Nature (2019) https://doi.org/10.1038/s41586-019-1791-1 |
Tags:
Medical Science